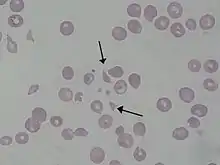

Schizocyte
Les schizocytes sont des fragments de globules rouges (GR ou hématies). Ils constituent une des anomalies de forme des hématies, et sont caractérisés par une cassure rectiligne du disque habituel, conséquence d'une fragmentation contre une paroi anormale des vaisseaux sanguins ou bien contre un filament de fibrine intra-vasculaire anormalement présent. Au lieu de se présenter sous forme d'un disque régulier, l'hématie va alors se caractériser par des bords souvent déchiquetés, de forme extrêmement variable et décrits sous des noms divers (kératocyte, horn cell). Lorsque le globule plus ou moins entier semble contracté, on parle de « pycnocyte » en particulier chez le très jeune enfant. La présence de schizocytes est détectée sur un frottis sanguin, lui même réalisé à partir d'une prise de sang au laboratoire d'analyses médicales ou dans un service de soin. Une observation au microscope est nécessaire. Ces fragments d'hématies sont alors facilement observables. Ils sont presque toujours anormaux, surtout si >1 % des hématies et en l'absence d'autres anomalies morphologiques, et la cause de leur origine doit être recherchée en urgence.
La schizocytose est rencontrée dans certaines anémies, notamment les anémies dites de cause mécanique, mais aussi les thalassémies, les maladies de la moelle osseuse avec fibrose... Les anémies d'origine mécanique sont surtout représentées par les anémies thrombotiques microangiopathiques[1] elles-mêmes subdivisées en purpura thrombotique thrombocytopénique (PTT ou syndrome de Moschcowitz) et les syndromes hémolytiques et urémiques (SHU). Ce sont deux urgences médicales, car les fragments sont rigides, et vont emboliser dans les petits capillaires et provoquer des défaillances d'organes (rein, cerveau, cœur, etc.).
Le terme schizocyte vient du grec 'σχίζειν' : cassure, et 'κυτε' : cellule.
Articles connexes
- Anomalie de forme des globules rouges (Poïkilocytose) :
- anomalie de membranes : Acanthocyte, Codocyte, Ovalocyte, Sphérocyte ;
- déformations de cause traumatique : Dacryocyte, schizocyte.
Notes et références
- Cet article est partiellement ou en totalité issu de l'article intitulé « Schizocytose » (voir la liste des auteurs).
- Zini G, d’Onofrio G, Briggs C, et al. ICSH recommendations for identification, diagnostic value, and quantitation of schistocytes, Int J Lab Hematol, 2012;34:107-16
- Portail de la médecine
- Portail de l’hématologie